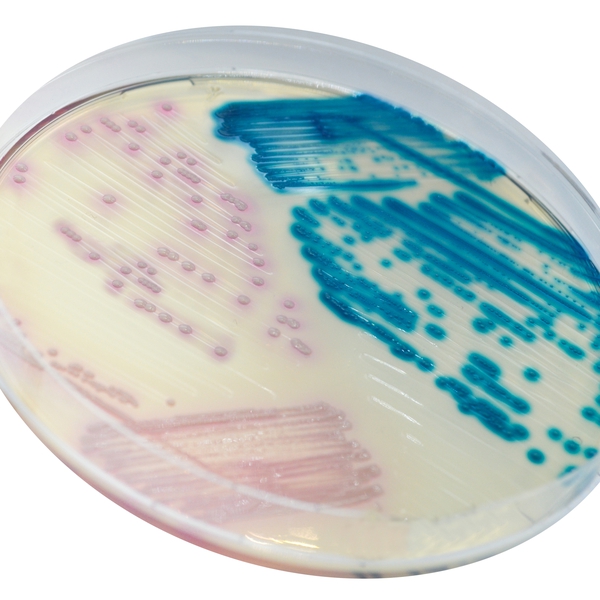
CHROMagar™ LIN-R

Colonies Appearance

LZDR Enterococcus
metallic blue

LZDR S. aureus, S. epidermidis
pink
Performance
Performance
Gram (+) cocci pose a global threat to human health due to the emergence of resistance to antibiotics. Linezolid has a broad spectrum of activity against a variety of pathogenic Gram (+) microorganisms, such as MRSA, VRS, and VRE. However, the emergence of strains resistant to linezolid (LIN-R) and horizontal spread of resistance linked to the cfr gene, have been increasingly reported after approval of its clinical use.
Although the prevalence of linezolid resistance remains low, the emergence of LIN-R strains is still of great concern. Today, linezolid sensitivity in Gram (+) clinical specimens is primarily monitored by surveillance programs in Europe and in the United States. Clinical isolates for surveillance of LIN-R strains include swabs from the nose (for screening of Staphylococcus), perianal and rectal areas (for screening of Enterococcus).
CHROMagar™ LIN-R is a chromogenic screening medium for the detection, isolation and differentiation of strains of Staphylococcus and Enterococcus resistant to linezolid.
1. Highly sensitive: Detection of MIC as low as 8 μg/mL.
3. Easy interpretation: Species identification by MALDI-TOF can be carried directly for a colony.
Composition

Technical Documents
Scientific Publications
2023
CHROMAgar™ LIN-R as an efficient screening tool to assess the prevalence of linezolid-resistant enterococci in German hospital patients—a multicentre study approach, 2021–2022
📄 Publication2023
Results of the German multicenter study using CHROMagar™LIN R to detect linezolid resistant enterococci
📄 Publication2022
Evaluation of CHROMagar™ LIN-R for the Screening of Linezolid Resistant Staphylococci from Positive Blood Cultures and Nasal Swab Screening Samples
📄 Publication2022
Dépistage de la résistance au linézolide : évaluation d’un milieu chromogène sélectif
📄 Publication2021
Excellent performance of CHROMagar LIN-R to selectively screen for linezolid-resistant enterococci and staphylococci
📄 Publication2021
Prevalence of linezolid-resistant organisms among patients admitted to a tertiary hospital for critical care or dialysis
📄 Publication

Read more